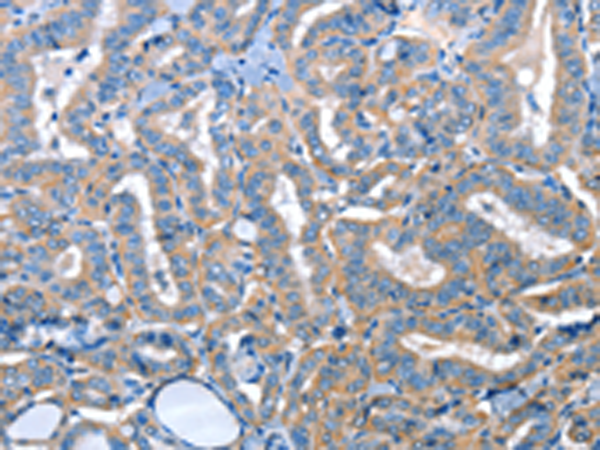

中文名稱:兔抗ADH4多克隆抗體
|
Background: |
This gene encodes class II alcohol dehydrogenase 4 pi subunit, which is a member of the alcohol dehydrogenase family. Members of this enzyme family metabolize a wide variety of substrates, including ethanol, retinol, other aliphatic alcohols, hydroxysteroids, and lipid peroxidation products. Class II alcohol dehydrogenase is a homodimer composed of 2 pi subunits. It exhibits a high activity for oxidation of long-chain aliphatic alcohols and aromatic alcohols and is less sensitive to pyrazole. This gene is localized to chromosome 4 in the cluster of alcohol dehydrogenase genes. |
|
Applications: |
ELISA, IHC |
|
Name of antibody: |
ADH4 |
|
Immunogen: |
Fusion protein of human ADH4 |
|
Full name: |
alcohol dehydrogenase 4 (class II), pi polypeptide |
|
Synonyms: |
ADH-2 |
|
SwissProt: |
P08319 |
|
ELISA Recommended dilution: |
2000-5000 |
|
IHC positive control: |
Human thyroid cancer and human lung cancer |
|
IHC Recommend dilution: |
25-100 |
購物車
購物車 幫助
幫助
 021-54845833/15800441009
021-54845833/15800441009
